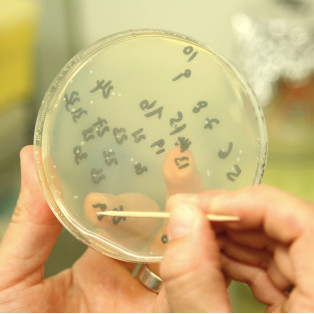

Biologics Products

Somos distribuidores autorizados de la marca Biologics Products para el estado de Quintana Roo. Biologics Products es una empresa dedicada a la fabricación y comercialización de aditivos naturales para brindar soluciones ambientales en el tratamiento y control de aguas residuales, desechos orgánicos, agricultura (mejora de suelos), producción animal, desinfección y eliminación de malos olores.
Los productos de Biologics Products cuentan con las siguientes certificaciones internacionales:
Productos
-
01.
Micronutrientes
Estimulan las bacterias propias del desecho, acelerando hasta en un 650% su proceso de degradación. Utilizados para el control y degradación de lodos, grasas y otros desechos orgánicos en trampas, cárcamos, drenajes, fosas sépticas, pozos de absorción y plantas de tratamiento.
BLASTER 300 | SRC | LPT | SSR -
02.
Desinfectantes y Sanitizantes
Son efectivos para eliminar hongos, algas, virus y bacterias, no afectan a la salud, no contaminan y son utilizados para desinfectar alimentos, utensilios de cocina, aires acondicionados, mesas de trabajo, cocinas, baños, habitaciones, cámaras frías, almacenes secos, auditorios y hasta quirófanos, por mencionar algunos.
TIMSEN | DISINFECTSAFE | AQUASAFE | EATSAFE -
03.
Bacterias
Son 29 especies de bacterias en estado adulto y se adaptan rápidamente a los diferentes medios. Se utilizan principalmente para plantas de tratamiento, la bio-remediación de suelos y cuerpos de agua contaminados, lagunas de oxidación y para el mejoramiento de césped y flores.
ACF-32 | SLUDGE AWAY | SOIL REMEDIATION -
04.
Limpieza
Productos 100% biodegradables, amigables con el ambiente y la salud del ser humano. Contamos con desengrasantes, productos de lavandería, limpiadores de alfombras, vidrios y acero, jabones neutros, limpieza de manos, aromatizantes, entre muchos otros productos.
¿Requiere alguna asesoría?
Contamos con la asesoría de biólogos expertos para el análisis de aguas residuales, control de descargas, cumplimiento de normas ambientales y control de olores en general, quienes le ofrecerán una solución a su problema.




